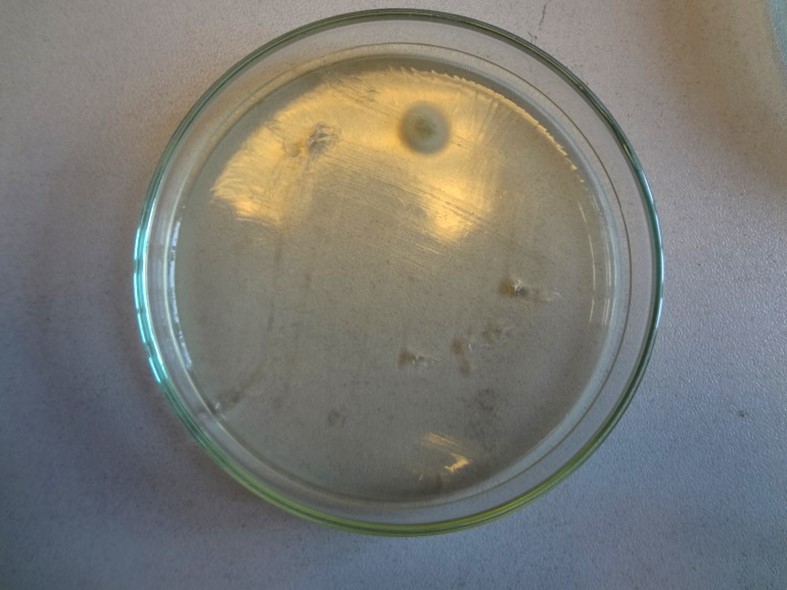

Na malbě jsou patrné stopy po plísních ve formě černých skvrn. Na fotografii jsou některá ložiska vyznačena šipkami.

Pomocí sterilních vatových tampónů byly provedeny stěry.

Pomocí sterilních vatových tampónů byly provedeny stěry.
Takto získané pevné částice byly převedeny na povrch sladinového živného agaru. Po čtrnáctidenní inkubaci mohli odborníci konstatovat, že byl ve vzorcích nalezen jen jeden živý zárodek, což je zanedbatelné množství.